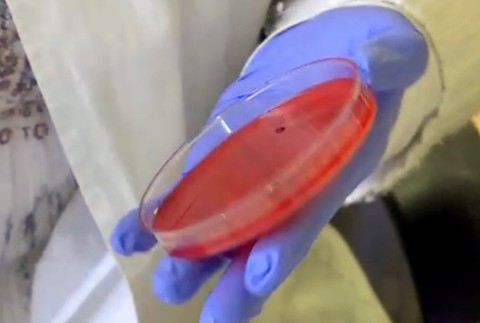
Pacienti si počkajú na diagnostiku. Nemocnice rušia niektoré oddelenia

Pacienti si na diagnostiku počkajú. Nemocnice rušia niektoré oddelenia
Máte vypnuté reklamy
Vďaka financiám z reklamy prinášame kvalitné a objektívne informácie. Povoľte si prosím zobrazovanie reklamy na našom webe. Ďakujeme, že podporujete kvalitnú žurnalistiku.
KOMÁRNO / Celoslovenský trend centralizácie laboratórií klinickej mikrobiológie môže mať za následok odďaľovanie diagnostiky. Vzorky odobraté pacientom sa preto prevážajú aj niekoľko hodín. Komárno je jedným z miest, kde takéto laboratórium od januára končí.
"Mikrobiológia je vedný odbor, ktorý sa zaoberá stanovením baktérií, vírusov, kvasiniek, plesní, parazitov v biologických vzorkách," uviedla Mónika Czirfusz, primárka oddelenia klinickej mikrobiológie, Komárno. Mikrobiologická diagnostika funguje v Komárne od roku 1952. "Hlavným problémom nášho oboru je podfinancovanie výkonov a nedostatok legislatívneho usmernenia," poznamenala Mónika Czirfusz. Nemocnica Komárno požiadala zdravotné poisťovne o odzmluvnenie oddelenia klinickej mikrobiológie k 1.januráu 2019. Po 66 rokoch tak mikrobiologické laboratórium v Komárne zanikne. "Uzatvorenie pracoviska nebude mať žiadny dopad na kvalitu starostlivosti o pacientov. Všetky mikrobiologické vyšetrenia budú naďalej k dispozícii v požadovanej kvalite a čase," informovala Alžbeta Sivá, hovorkyňa nemocnice Komárno.
Pacienti si počkajú na diagnostiku. Nemocnice rušia niektoré oddelenia
Hemokultúry budú voziť do zmluvného pracoviska vo Zvolene, vzdialeného 150 kilometrov. Štandardný postup pre laboratórnu diagnostiku v klinickej mikrobiológii ale jasne definuje čas spracovania vzoriek pre relevantný výsledok. "Pri tých vzorkách je do tých 30 minút, maximálne do 2 hodín, to je naozaj ten horný limit transportu," vysvetlila primárka oddelenia klinickej mikrobiológie. Pri nedodržaní štandardu časov, môže na to doplatiť pacient. "Čím dlhšie stojí tá hemokultúra na stole, tým ten pacient stráca čas," dodala Mónika Czirfusz.
Novovytvorený diagnostický štandardný postup z odbornej skupiny pre klinickú mikrobiológiu počíta s vytvorením funkčnej siete laboratórií. "V zmysle novovytvoreného postupu by mali mať všeobecné nemocnice s akútnou starostlivosťou vlastné mikrobiologické laboratórium, alebo externým poskytovateľom, v sídle nemocnice," povedala Zuzana Eliášová, hovorkyňa ministerstva zdravotníctva SR.
Z biologických materiálov sa zisťujú pôvodcovia infekčných ochorení a na základe toho lekári navrhujú účinnú terapiu. V Komárne petíciu za zachovanie oddelenia klinickej mikrobiológie v nemocnici podpísalo už 3000 ľudí. Pripomienky Slovenskej spoločnosti klinickej mikrobiológie budú prerokované na stretnutí s ministerkou zdravotníctva v januári.
Viac ako 136-tisíc hygienických balíčkov bolo v nemocniciach rozdelených ešte v októbri. Zásoby sa ale míňajú: